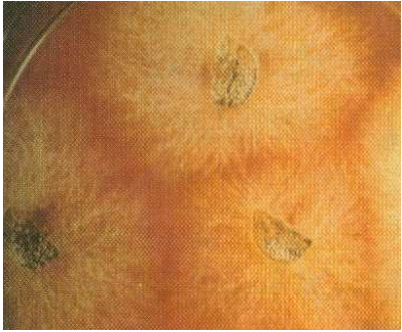

الفاكهة والاشجار المثمرة


نخيل التمر

النخيل والتمور

آفات وامراض النخيل وطرق مكافحتها

التفاح

الرمان

التين

اشجار القشطة

الافو كادو او الزبدية

البشمله او الاكي دنيا

التوت

التين الشوكي

الجوز

الزيتون

السفرجل

العنب او الكرمة

الفستق

الكاكي او الخرما او الخرمالو

الكمثري(الاجاص)

المانجو

الموز

النبق او السدر

فاكة البابايا او الباباظ

الكيوي


الحمضيات

آفات وامراض الحمضيات

مقالات منوعة عن الحمضيات


الاشجار ذات النواة الحجرية

الاجاص او البرقوق

الخوخ او الدراق

الكرز

المشمش

مواضيع عامة

اللوز

الفراولة او الشليك

الجوافة

الخروب(الخرنوب)

الاناناس

مواضيع متنوعة عن اشجار الفاكهة

التمر هندي

الكستناء

شجرة البيكان ( البيقان )

البندق


المحاصيل


المحاصيل البقولية

الباقلاء (الفول)

الحمص

الترمس

العدس

الماش

اللوبياء

الفاصولياء

مواضيع متنوعة عن البقوليات

فاصوليا الليما والسيفا

محاصيل الاعلاف و المراعي


محاصيل الالياف

القطن

الكتان

القنب

الجوت و الجلجل

محصول الرامي

محصول السيسال

مواضيع متنوعة عن محاصيل الألياف


محاصيل زيتية

السمسم

فستق الحقل

فول الصويا

عباد الشمس (دوار الشمس)

العصفر (القرطم)

السلجم ( اللفت الزيتي )

مواضيع متنوعة عن المحاصيل الزيتية

الخروع


محاصيل الحبوب

الذرة

محصول الرز

محصول القمح

محصول الشعير

الشيلم

الشوفان (الهرطمان)

الدخن


محاصيل الخضر

الباذنجان

الطماطم

البطاطس(البطاطا)

محصول الفلفل

محصول الخس

البصل

الثوم


القرعيات

الخيار

الرقي (البطيخ الاحمر)

البطيخ

آفات وامراض القرعيات

مواضيع متنوعة عن القرعيات

البازلاء اوالبسلة

مواضيع متنوعة عن الخضر

الملفوف ( اللهانة او الكرنب )

القرنبيط او القرنابيط

اللفت ( الشلغم )

الفجل

السبانخ

الخرشوف ( الارضي شوكي )

الكرفس

القلقاس

الجزر

البطاطا الحلوه

القرع

الباميه

البروكلي او القرنابيط الأخضر

البنجر او الشمندر او الشوندر

عيش الغراب او المشروم او الأفطر


المحاصيل المنبهة و المحاصيل المخدرة

مواضيع متنوعة عن المحاصيل المنبهة

التبغ

التنباك

الشاي

البن ( القهوة )


المحاصيل السكرية

قصب السكر

بنجر السكر

مواضيع متنوعة عن المحاصيل


نباتات الزينة والنباتات الطبية والعطرية

نباتات الزينة

النباتات الطبية والعطرية


الحشرات النافعة


النحل

نحل العسل

عسل النحل ومنتجات النحل الاخرى

آفات وامراض النحل


دودة القز(الحرير)

آفات وامراض دودة الحرير

تربية ديدان الحرير وانتاج الحرير الطبيعي


تقنيات زراعية

الاسمدة

الزراعة العضوية

الزراعة النسيجية

الزراعة بدون تربة

الزراعة المحمية

المبيدات الزراعية

انظمة الري الحديثة


التصنيع الزراعي

تصنيع الاعلاف

صناعات غذائية

حفظ الاغذية


الانتاج الحيواني


الطيور الداجنة

الدواجن

دجاج البيض

دجاج اللحم

امراض الدواجن


الاسماك

الاسماك

الامراض التي تصيب الاسماك


الابقار والجاموس

الابقار

الجاموس

امراض الابقار والجاموس


الاغنام

الاغنام والماعز

الامراض التي تصيب الاغنام والماعز


آفات وامراض النبات وطرق مكافحتها


الحشرات

الحشرات الطبية و البيطرية

طرق ووسائل مكافحة الحشرات

الصفات الخارجية والتركيب التشريحي للحشرات

مواضيع متنوعة عن الحشرات

انواع واجناس الحشرات الضارة بالنبات

المراتب التصنيفية للحشرات


امراض النبات ومسبباتها

الفطريات والامراض التي تسببها للنبات

البكتريا والامراض التي تسببها للنبات

الفايروسات والامراض التي تسببها للنبات

الاكاروسات (الحلم)

الديدان الثعبانية (النيماتودا)

امراض النبات غير الطفيلية (الفسيولوجية) وامراض النبات الناتجة عن بعض العناصر

مواضيع متنوعة عن امراض النبات ومسبباتها


الحشائش والنباتات الضارة

الحشائش والنباتات المتطفلة

طرق ووسائل مكافحة الحشائش والنباتات المتطفلة

آفات المواد المخزونة

مواضيع متنوعة عن آفات النبات

المكائن والالات الزراعية

مواضيع متنوعة عن الزراعة
مرض البيوض أو مرض الفيوزاريوز الذي يصيب النخيل
المؤلف:
محمد محمود الزيات واخرون
المصدر:
أهم أمراض وآفات نخيل التمر بالمملكة العربية السعودية وطرق مكافحتها المتكاملة
الجزء والصفحة:
...
10-1-2016
14249
مرض البيوض Bayoud Disesse
أو مرض الفيوزاريوز Fusariose Disease
لقد اشتق اسم هذا المرض " البيوض Bayoud " من الكلمة العربية " ابيض Abiadh " وهي تعني ابيضاض سعف جريد النخيل المصاب.
التوزيع الجغرافي للمرض:
أكتشف هذا المرض لأول مرة في جنوب المغرب منذ عام 1870م بوادي درعا شمال زاجوره، ثم انتشر بعد ذلك بصورة وبائية شرقاً وغرباً، حيث أتى هذا المرض في المغرب على ثلثي بساتين النخيل هناك وبما يقدر بحوالي 12 مليون نخلة خلال قرن من الزمان، ثم تقدم المرض شرقاً في اتجاه الواحات الجزائرية مدمرا في طريقه جزءا كبيراً من بساتين النخيل من اجود الاصناف مثل دجلة نور وغيرها وعم الجنوب والوسط الجزائري حتى حدود تونس واهلك اكثر من 3 ملايين شجرة بالجزائر، ومازال هذا المرض مستمرا الانتشار في تلك المناطق مما ادى الى تدهور انتاج التمور وفقد خصوبة التربة و افتقار العائلات بل و نزوحها من تلك المناطق التي عاشو فيها سنوات طويلة.
وقد ظهر هذا المرض بعد ذلك في موريتانيا، ثم ظهر في اوربا على نخيل جزر الكناري Date Palm, Phoenix canariensis Chabaud Canary في كل من فرنسا وايطاليا.
وحديثاً انتقل هذا المرض الى داخل القارة الافريقية حيث ثبت عام 2000 م وجود هذا المرض في نيجيريا( Omamor,2000).
المسبب المرضي:
يسبب هذا المرض الفطر فيوزاريم أوكسيبورم فورما إسبيشز البيدينس
Fusarium oxysporum f. sp. albedinis Malencon
(Fusarium oxysporum Schlect.var. albedinis (Killian & Maire) Malencon
وهو فطر من فطريات التربة الذي يتبع الفطريات الناقصة (Impefect Fugi ) من التربة Moniliales ومن العائلة Tuberculariaceae. ويتميز في نموه الخضري بتكوين ميسليوم رقيق وشفاف يتكون من هيفات رفيعة تشبه خيوط القطن وهي مقسمة بجدر عرضية الى خلايا دقيقة، ويفرز صبغة وردية او بنفسجية في البيئة الصناعية التي ينمو عليها في المختبرات. كما يكون وسادات جرثومية كونيدية تعرف باسم أسبوردوكيا (Sporodochia) ومفردها أسبوردوكيوم (Sporodochium) وردية اللون او قرنفلية ضاربة للبرتقالي، وتتكون من حوامل الفطر الكونيدية التي تحمل نوعين من الجراثيم الكونيدية ، منها الحوامل التي تحمل الجراثيم الكونيدية الصغيرة Micoconidia والتي تتكون من خلية واحدة او خليتين، ومنها الحوامل التي تحمل الجراثيم الكونيدية الكبيرة Macroconidia والتي تتكون من جراثيم هلالية الشكل ومقسمة بجدر عرضية الى 6 -3 خلايا وقمتها مستدقة. الا ان معظم الجراثيم الكونيدية التي يكونها هذا الفطر بالبيئات الصناعية او بأجزاء شجرة النخيل المصابة تكون غالباً من نوع الجراثيم الصغيرة . كما يكون الفطر نوع من الجراثيم السميكة الجدر إما منفردة او في سلاسل تعرف بالجراثيم الكلاميدية Chlamydospores سواء في المزارع الفطرية القديمة او في التربة ، وهذه الجراثيم تنشأ من الميسليوم العادي او من خلايا الجراثيم الكونيدية الكبيرة ويمكنها المحافظة على حياة الفطر وبقائه لفترة طويلة. كذلك قد يكون الفطر في المزارع الفطرية أجساماً حجرية Sclerotia زرقاء الى سوداء اللون اما مجتمعة او موزعة على الميسليوم ، ويصل قطرها الى حوالي 1-3 سم، وهذه ايضا قادرة على حفظ الفطر حياً لفترة طويلة .
ويلاحظ ان العزلات المختلفة من هذا الفطر سريعة التغير في صفاتها عند اعادة زرعها على البيئات الصناعية وحتى داخل أجزاء النخلة المصابة. ويمكن عزل الفطر من التربة الموبوءة وكذلك من الانسجة الوعائية السمراء اللون بجميع اجزاء النخلة المصابة، وقد لوحظ ان السلالات التي يتم عزلها من التربة او الجذور او قاعدة جذع النخلة تكون اضعف في قدرتها المرضية عن السلالات التي يتم عزلها من قمة السعفة لنفس النخلة المصابة ، وهذا يعني ان الفطر يزداد نشاطه كلما تقدم في النخلة الى اعلى.
العوائل القابلة للإصابة : Host Range
يصيب هذا الفطر الممرض نخيل التمر .Phoenix dactylifera L ونخيل جزر الكناري Canary Date Palm, Phoenix canariensis Chabaud وكذلك يصيب كلا من البرسيم الحجازي ( الجت) Alfalfa, Medicago sativa L. والحناء Henna, Lawsonia inermis التي تنمو تح أشجار النخيل، حيث تم عزل الفطر من جذور النباتين الاخيرين ولكن دون ان يظهر عليهما اية اعراض مرضية، ولذلك فأن الفطر يمكن ان ينتقل منها الى النخيل.
الأعراض:
يهاجم المرض كلا من اشجار النخيل التامة النمو والفتية على حد سواء وكذلك الفسائل ويقضي عليها وتتمثل اعراض الإصابة بهذا المرض فيما يلي:
1- تظهر الأعراض اولاً على سعفة او اكثر حديثة النضج في منتصف رأس النخلة، حيث تظهر السعفة المصابة باللون الرمادي البني ثم تذبل بطريقة خاصة ، حيث يصبح بعض الخوص (الوريقات) او الأشواك على جهة واحدة من الجريدة أبيض اللون حيث يتقدم المرض من قاعدة السعفة الى قمتها ، ثم يبدأ الذبول على الجهة الأخرى متقدما في الاتجاه العكسي من القمة نحو القاعدة حتى تموت السعفة بكاملها.
2- تظهر خطوط بنية فاتحة يغمق لونها على امتداد السطح السفلي للجريد والذي يسمى بالسطح الظهري Dorsal Side ( وهو السطح المواجه للتربة) اثناء عملية الابيضاض وموت الخوص وهذه تمتد من القاعدة الى القمة في مقابل مرور ميسليوم الفطر بالحزم الوعائية للجريد.
3- حينئذ تتقوس السعفة وتأخذ شكلاً مميزا حيث يلتصق الخوص عليها فتشبه بذلك ريشة الدجاج المبللة بالماء، وتتدلى الى اسفل باتجاه جذع النخلة. وهذا يستغرق بضعة ايام الى عدة اسابيع، ثم تتوالى الاعراض على السعف المجاور او المقابل حتى تصل الى البرعم الطرفي للنخلة ، وبذلك تموت النخلة بعد فترة تمتد من ستة اشهر الى سنتين منذ بدء ظهور الاعراض، ولا تعيش لأكثر من خمس سنوات.
4- قد تتطور الاعراض بشكل مختلف احياناً حيث تظهر الصبغة البنية الداكنة في وسط الجريدة من الخلف وليس على جهة واحدة، كما قد يلاحظ اصفرار عام بالسعف قبل ظهور الاعراض النموذجية للمرض خصوصاً في الخريف والشتاء. وبعد موت النخلة تظهر الاعراض على الفسائل القاعدية التي قد تموت في خلال سنة.
5- عند عمل قطاع عرضي بالجذور او بجذع النخلة او في السعفة يلاحظ تلون الحزم الوعائية والانسجة البرنشيمية المحيطة بها بلون بني ضارب للحمرة.
وسائل انتقال المرض Transmission
الفطر المسبب لهذا المرض هو فطريات التربة الذي يمكنه البقاء بها على صورة جراثيم كلاميدية لسنوات طويلة وكذلك في بقايا النباتات المصابة. ويبدأ في النشاط من جديد عند زراعة النخيل بها حيث يصيب الاشجار من جديد. وينتقل المرض في نفس الموقع من الاشجار المصابة الى الاشجار السليمة من خلال تلاقي الجذور Root contact للأشجار المتجاورة، كما ينتشر المرض من منطقة لأخرى بانتقال التربة الملوثة عن طريق الرياح او بمياه الري او الآلات الزراعية او الحيوانات وعل ى أرجل العمال وكذلك ينتقل في اجزاء الأشجار المصابة او الأدوات المصنوعة منها ، هذا علاوة على الانتقال بسهولة بالفسائل المصابة. كما تزداد شدة الاصابة بهذا المرض بزيادة الري خاصة عند تحميل بعض المحاصيل الاخرى على اشجار النخيل لأن المزارع يضطر الى تكرار ري هذه المحاصيل على فترات متقاربة.
المكافحة المتكاملة للمرض:
هذا المرض في غاية الخطورة عند ظهوره في منطقة ما، ونظرا لوجود الفطر الممرض في الجذور و على أبعاد كبيرة بالتربة الموبوءة التي يصعب الوصول اليها بأي معاملة بما في ذلك المبيدات، كما أنه يكون وحدات ساكنة يمكنها البقاء في التربة لفترات طويلة ، لذلك يتطلب الأمر إتباع الآتي:
1- ضرورة الالتزام بقوانين الحجر الزراعي الدولي بكل حزم واصرار ومنع دخول اشجار النخيل او اجزائها على اية صورة او منتجاتها الى المملكة.
2- عند اكتشاف اصابة أولية بالمرض يجب تقليع الاشجار وحرقها في مكانها ثم تطهير التربة لعمق 1,5م بأحد المبيدات الفعالة.
3- لا يفيد كثيراً معاملة الفسائل او الاشجار بالمبيدات الفطرية في مكافحة هذا المرض نظراً لتعمق جذور النخيل بالتربة.
4- تتجه الانظار الى نتائج دراسة المقاومة الوراثية وانتاج اصناف تمور مقاومة للمرض في دول المغرب العربي تكون جيدة الصفات لزراعتها هناك بعد ان اصبح المرض خطراً يهدد مستقبل هذه الشجرة المباركة في المناطق الموبوءة ببعض دول المغرب العربي.
أعراض الإصابة بمرض البيوض على نخيل التمر

ابيضاض السعف الداخلي بمنتصف رأس النخلة والذي يبدأ على احدى جانبين السعفة المصابة ثم يتجه للجانب الاخر

يتقدم المرض بسرعة على النخلة المصابة ويتقوس السعف المصاب ويلتصق الخوص ليشبه ريشة الدجاج المبلل ويتدلل لأسفل وذلك خلال عدة أيام الى بضعة اسابيع

المرحلة الاخيرة من تطور مرض البيوض تنتهي بموت البرعم الطرفي للنخلة

قطاع عرضي في جذع نخلة يبين تلون الحزم الوعائية المصابة بالفطر الممرض
نمو الفطر الممرض في بيئة صناعية بالعمل
المصدر: أهم أمراض وآفات نخيل التمر بالمملكة العربية السعودية وطرق مكافحتها المتكاملة 2002. محمد محمود الزيات ، صالح ابراهيم القعيط ، د. حسن عصام الدين متولي لقمه، د. هاني عبد الرحمن ظفران و أ د. . خالد سعد آل عبد السلام.
الاكثر قراءة في آفات وامراض النخيل وطرق مكافحتها
اخر الاخبار
اخبار العتبة العباسية المقدسة
الآخبار الصحية

قسم الشؤون الفكرية يصدر كتاباً يوثق تاريخ السدانة في العتبة العباسية المقدسة
"المهمة".. إصدار قصصي يوثّق القصص الفائزة في مسابقة فتوى الدفاع المقدسة للقصة القصيرة
(نوافذ).. إصدار أدبي يوثق القصص الفائزة في مسابقة الإمام العسكري (عليه السلام)